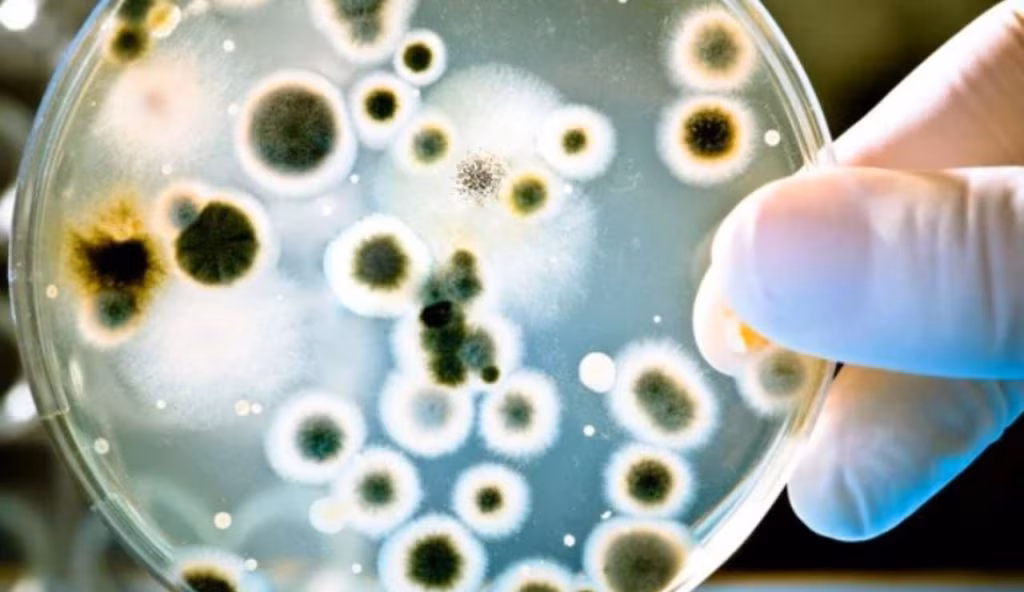

Altro che spugna della cucina: l’oggetto più sporco di tutti lo tieni sempre in mano | Ci sono germi dovunque, anche dove non pensavi
Batteri (Depositphotos foto) - www.biomedicalcue.it
Pensavi fosse la spugna da cucina, invece l’oggetto pieno di batteri è sempre tra le tue mani: fai attenzione.
Ci sono oggetti che usiamo in continuazione, senza nemmeno farci caso. Gesti automatici, così ripetitivi da sembrare innocui. Ma lo sono davvero? Uno in particolare è sempre con noi, ce lo portiamo ovunque – sul divano, in bagno, a cena fuori – eppure non ci chiediamo mai cosa si stia “appiccicando” sulla sua superficie.
Siamo attentissimi a igienizzare i piani della cucina, a spruzzare disinfettanti in bagno, a lavarci le mani dopo essere usciti. Ma intanto c’è una cosa che tocchiamo continuamente e che, paradossalmente, sfugge del tutto al nostro radar dell’igiene. E la teniamo addosso praticamente tutto il giorno.
Il punto è proprio questo: lo tocchiamo noi, ma anche altre persone, lo appoggiamo ovunque – sì, anche su sedili sporchi, pavimenti, tavoli pubblici – e lui, silenziosamente, accumula tracce di tutto ciò con cui entra in contatto. Ci passa davanti agli occhi di continuo… eppure non vediamo nulla. Ma invisibile non vuol dire pulito.
Anzi, è proprio lì che si nasconde il problema: sulle superfici più familiari si crea un vero microcosmo batterico, del tutto invisibile ma molto presente. E no, non serve andare nel panico. Ma almeno sapere cosa c’è sopra potrebbe farci cambiare qualche abitudine.
Quello che non ti aspetti
Come riporta GreenMe, a farci sbirciare in questo mondo invisibile ci ha pensato Doctor Microscope, creator italiano su TikTok che condivide video educativi usando il microscopio. In uno dei suoi ultimi esperimenti ha messo sotto la lente questo oggetto, mostrando cosa si nasconde sulla sua superficie dopo averlo trattato con blu di metilene, una sostanza che “colora” i batteri per renderli visibili.
Il risultato? Una vera… ehm, come chiamarla… colonia in piena espansione. Dallo schermo emerge un’alta concentrazione di batteri appartenenti alla famiglia dei cocchi — singoli, in coppia o in catena — normalmente presenti sulla nostra pelle, ma capaci di causare infezioni se trovano l’occasione giusta (tipo piccole ferite o difese immunitarie basse). Ma come possiamo agire?

Cosa succede davvero e come agire
Il meccanismo è tanto semplice quanto inquietante: ogni volta che sfioriamo lo schermo dello smartphone — anche con le mani appena lavate, pensa te — trasferiamo minuscoli batteri. E se il telefono finisce sul tavolo del bar, viene prestato a qualcuno, o passa un po’ di tempo sul pavimento… be’, la popolazione batterica sale in fretta. Al punto che sì, potrebbe essere tra gli oggetti più contaminati che possediamo.
Cosa possiamo fare? Niente di folle, tranquilli. Basta prendere l’abitudine di pulire il telefono con prodotti a base alcolica, evitare di appoggiarlo ovunque capiti e magari ricordarsi di lavarsi le mani prima e dopo l’uso. Roba semplice, ma che può davvero fare la differenza.